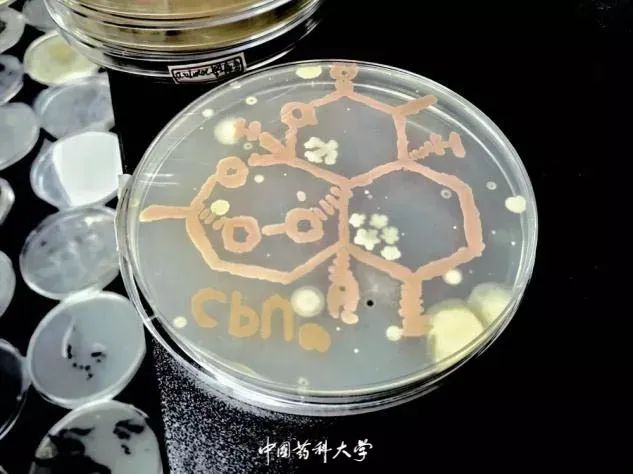
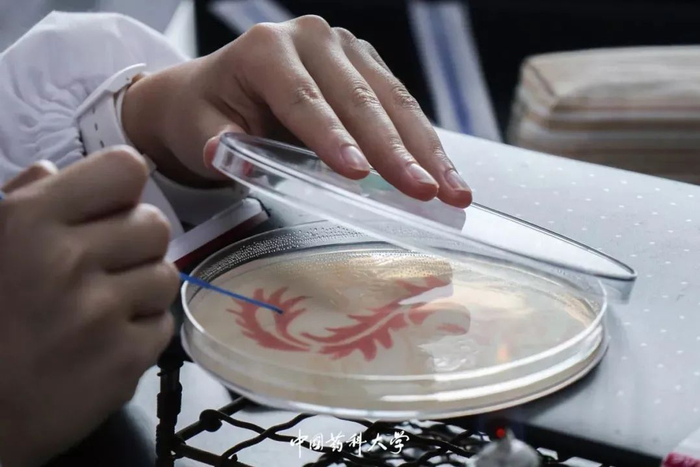

原标题:2020新生开学攻略(二)|药苑24时,生活指南
来源:中国药科大学
6:00
窗外清脆的鸟叫声是清晨的号角,轻轻唤醒睡梦中的药大人,晨曦刚刚亲吻大地,伴着微风和尚未散去的薄雾。在开学后不久,萌新们会迎来军训,目视前方,整齐划一,英姿飒爽,意志坚定,昂首阔步,这便是青春最美的模样。
7:00
洗漱完毕,和两三好友说说笑笑离开寝室,路过文印店,提前复印好上课需要的知识讲解。学校里一共有两间文印店,分别在B组团、F组团宿舍楼下,除此之外,图书馆二楼还有自助打印机,方便同学们在图书馆学习的同时打印资料。
接下来就是早餐时间,江宁校区有两个食堂,分别是第一食堂和第二食堂,两个食堂相邻,均有三层楼,我们习惯上把一食堂一楼称为1.1,一食堂二楼称为1.2,依此类推,1.3的供应对象主要是老师,学生也可以在1.3就餐。
步入食堂,你可以很容易地捕捉到食物的香气,阿姨已早早在窗口摆上了丰富的早餐。玉米、煎包、煎饼……无论是你偏爱的豆浆、包子,还是喜爱的饺子,抑或是情有独钟的馍,这里一应俱全,大家记得吃早餐哦。
8:00
早餐之后,新的一天学习正式开始,学校有A、B、C、D、E五栋教学楼,灰色的色调,不失简约大气,学生可根据课表上的安排,前往对应的教室上课。
9:00
讲台上的老师循循善诱,座位上的同学聚精会神,紧紧跟随老师的思路,飞速在笔记本上记下重点内容,课上种下认真听课的种子,期末就能收获优异成绩的果实。
10:00
课间休息片刻,放松一下自己,去看看教室外的风景是一个不错的选择。抬头便是湛蓝的天空,朵朵白云自由飘荡,尽情舒展;低头览药大美景,阳光明媚,花开正好,俯仰之间,景色尽收眼底。
11:00
高颜值的网红教室供你尽情享受。小组式教学,方便讨论和交流,老师还会有效利用雨课堂一类微信小程序增强和学生之间的互动。教室前方的白板以及前后左右的电子屏幕,确保每一位学生无论坐在哪里,都能直观看到授课内容,带来学习新体验。
12:00
午饭时间,你还在为中午吃什么而苦恼吗?民族餐厅、特色风味餐厅、奶茶店、烘培店一应俱全。2.1森系音乐餐厅,音乐演出为你而来,似乎餐盘中的美食都香了许多;2.2生命之树主题餐厅,巨大的树形柱坐落在餐厅中央,包含对生命的敬畏之意;2.3梦幻花园餐厅,打造樱花世界,满满的浪漫氛围,除了吃饭,也不失为一个学习的好去处。
牛肉汤、酱汁排骨煲仔饭、油泼面……还有倍受赶时间同学欢迎的快餐,不仅仅是美味,更是实惠,饭后一杯柠檬茶饮,妥妥的夏天消暑神器,或者到烘焙店里走一圈,买些小面包,甜甜的食物总会让人愉悦。
13:00
午休半小时,下午精力更充沛。学校有A、B、C、D、E、F、G、H学生公寓组团,还有一个留学生组团,每个组团门口均设置有人脸识别系统,方便又安全,寝室均为上床下桌的形式,内有空调,配备有热水器,还有生活阳台,每个同学都有独立衣柜。
关于校内无线网络,全校(除宿舍区外)都覆盖CPU无线网络,若从校外网络访问校内平台系统,则需要使用VPN方法登陆校园网。该VPN系统使用简单便捷,仅通过网页浏览器进行登录即可访问校内相关资源、查阅图书馆电子文献。使用说明如下:
通过浏览器访问(仅能在校外访问)
https://vpn.cpu.edu.cn/danana/auth/url_default/welcome.cgi,该VPN系统是为了方便从校外访问校内资源。关于通讯与网络,学校内三家运营商(移动、电信、联通)为大家提供通讯与宽带服务,宿舍接口通用。
安全、干净、宜人、舒适,精致宿舍,你值得拥有。
14:00
药大只有理论课、实验课?当然不是,学校还有丰富的体育课,自主选择网球、击剑、高尔夫……总有一项运动适合你。只见同学左手将球高高抛起,右手甩起球拍,一个猛扣,完美的一击;击剑运动要求击剑人员不断观察、不断思考、迅速做出反应,拥有极强的技巧性;胳膊伸直,腿稍微弯曲,球杆平面与地面水平,胳膊旋转45°,弯曲上升,再向下一挥手,球就顺势飞出。没有练习过这些运动的萌新也不必担忧,体育老师会给予耐心的指导。
15:00
理论知识要掌握,动手实践同等重要,药大的实验课乐趣无穷。在实验中见证美丽的颜色变化,你会发现,曾经只出现在课本上的器材也会出现在你的实验台上,化学反应带来的奇妙现象会让你感慨万物的神奇。
不仅仅是课堂内,课余时间的学校活动同样让你体验实验的乐趣,“皿上添花”是最受欢迎的活动之一,左手皿,右手菌,它带你探索培养皿中微观世界的奥秘,一起来绘出属于自己独一无二的图案!
16:00
炎炎午后,想寻一处适合学习的清凉地,图书馆和自修室就是最好的选择。各种书籍整齐摆放,不论你是想查阅文献,还是想安静读书,都能在这里收获满足,图书馆的一楼还有霍格沃兹同款自修室,浓浓的学术氛围让你不自觉想要认真地学习,虽然自修室和图书馆的座位很多,但是也经常会出现满员的情况,所以不要忘了提前预约呀~(想知道更多关于图书馆的详细介绍,请阅读新生指南第一期)
17:00
药大人在专注学业的同时,在社团活动方面也毫不逊色,药大社团遍地开花,课后的空余时间常常可以看到许多不同的社团活动,它们不仅可以让你get一些新技能,而且能够认识志同道合的朋友,在活动中大展身手。
18:00
阳光的余晖洒在墙壁上,健美操的同学正在训练,富有技巧的动作在一次次的重复中变得游刃有余;排球运动员训练对垒,总结动作要领;田径运动员在起跑线前蓄势待发。台上一分钟,台下十年功,没有什么荣誉能来的轻轻松松,但是我相信,付出总会得到回报,赛场上的你们一定是最耀眼的那颗星星。
19:00
夕阳西下,伴着天边粉红色的晚霞,赶在驿站关门前去取快递,等了许久的包裹终于到了,心里怀有些许小期待,它会是什么呢?
菜鸟驿站地址位于G组团文思苑前,需要注意的是,取件前请提前准备好证件(校园卡、身份证、医保卡、驾照、支付宝主页、淘宝主页、学生证等),取件时,需要带证件凭手机短信的取货码取件,取件后需要从出口处扫描出去,同时,菜鸟驿站可提供寄件服务,只需到菜鸟驿站前台找工作人员咨询即可,支付方式可现金、支付宝和微信。
学校详细地址:江苏省南京市江宁区龙眠大道639号中国药科大学
邮编:211198
在江宁校区学生公寓E组团(二食堂向北30米),你会看见校园综合服务大厅,这里为大家提供较全面的生活服务,对于后勤服务、校园卡等问题都可以在这里得到解决。